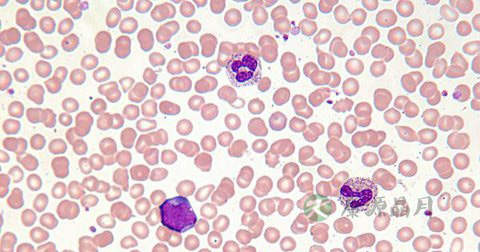

- 您好!欢迎来到康源名医金桥网

1、结核病是一种周身性的疾病,由于它是最容易经呼吸道传染,最初发生的结核病,常常是在肺部,因而结核病以肺结核最为常见。在病发展过程中,结核病可以从肺部在播散到身体的其他部分。近年来,随着结核病发病率的增高,肺结核会传染吗,肺结核如何治疗,成为人们关注的热点问题。
2、结核病是一种周身性的疾病,由于它是最容易经呼吸道传染,最初发生的结核病,常常是在肺部,因而结核病以肺结核最为常见。在病发展过程中,结核病可以从肺部在播散到身体的其他部分。近年来,随着结核病发病率的增高,肺结核会传染吗,肺结核如何治疗,成为人们关注的热点问题。

3、肺结核会传染,但不易传染。健康人接触了肺结核病人,或拿了病人用过的东西,如毛巾、玩具、手帕等,手上可能污染了结核菌,再用这污染的手拿东西吃或接触口鼻,也可能造成为胃肠传染或呼吸道传染。不过,结核病经这种方法传染的机会并不是太多。除了这种传染方式以外,结核菌也可以由皮肤或粘膜的伤口直接感染,有人把这种传染方法叫做“接种传染”。由于结核菌不能穿透完整的健康皮肤,这种传染也比较少见。
4、结核菌的主要来源除非结核病人吐出来的痰以外,肠结核病人的大便,肾结核病人的小便,以及淋巴结结核和骨结核的脓,都含有结核菌,也可以传染人。但传染的机会比起痰来要少得多,主要是因为这些东西不至于随地都有,也不容易被别人接触。
5、患者早期出现病变时体内含有的致病细菌比较多,致病细菌生长速度快,代谢活跃,使用药物治疗后效果较佳,易恢复。
6、不同细菌对对药物反应不同,因此患者要根据自身实际情况用药,治疗效果不佳,可根据医生指导联合用药,以防止耐药性产生;联合用药可针对各种代谢状态细菌及细胞内外菌选药,已达到强化药效的目的。
7、化疗是治疗肺结核的有效方法。在全程化疗过程中,患者都要保持乐观的心态,并且坚持治疗,不要中途放弃,这样才能达到消灭细菌,防止复发的目的。
1、症状
有较密切的结核病接触史,起病可急可缓,多为低热(午后为着)、盗汗、乏力、纳差、消瘦、女性月经失调等;呼吸道症状有咳嗽、咳痰、咯血、胸痛、不同程度胸闷或呼吸困难。
2、体征
肺部体征依病情轻重、病变范围不同而有差异,早期、小范围的结核不易查到阳性体征,病变范围较广者叩诊呈浊音,语颤增强,肺泡呼吸音低和湿啰音。晚期结核形成纤维化,局部收缩使胸膜塌陷和纵隔移位。在结核性胸膜炎者早期有胸膜摩擦音,形成大量胸腔积液时,胸壁饱满,叩诊浊实,语颤和呼吸音减低或消失。

3、肺结核的分型和分期
3.1、肺结核分型:原发性肺结核(Ⅰ型)肺内渗出病变、淋巴管炎和肺门淋巴结肿大的哑铃状改变的原发综合征,儿童多见,或仅表现为肺门和纵隔淋巴结肿大。
3.2、血型播散型肺结核(Ⅱ型)包括急性粟粒性肺结核和慢性或亚急性血行播散型肺结核两型。急性粟粒型肺结核:两肺散在的粟粒大小的阴影,大小一致密度相等,分布均匀的粟粒状阴影,随病期进展,可互相融合;慢性或亚急性血行播散型肺结核:两肺出现大小不一、新旧病变不同,分布不均匀,边缘模糊或锐利的结节和索条阴影。
3.3、继发型肺结核(Ⅲ型)本型中包括病变以增殖为主、浸润病变为主、干酪病变为主或空洞为主的多种改变。
3.4、浸润型肺结核:X线常为云絮状或小片状浸润阴影,边缘模糊(渗出性)或结节、索条状(增殖性)病变,大片实变或球形病变(干酪性—可见空洞)或钙化。
3.5、慢性纤维空洞型肺结核:多在两肺上部,亦为单侧,大量纤维增生,其中空洞形成,呈破棉絮状,肺组织收缩,肺门上提,肺门影呈“垂柳样”改变,胸膜肥厚,胸廓塌陷,局部代偿性肺气肿。
3.6、结核性胸膜炎(Ⅳ型)病侧胸腔积液,小量为肋膈角变浅,中等量以上积液为致密阴影,上缘呈弧形。
分期:进展期新发现的活动性肺结核,随访中病灶增多增大,出现空洞或空洞扩大,痰菌检查转阳性,发热等临床症状加重。好转期随访中病灶吸收好转,空洞缩小或消失,痰菌转阴,临床症状改善。稳定期空洞消失,病灶稳定,痰菌持续转阴性(1个月1次)达6个月以上;或空洞仍然存在,痰菌连续转阴1年以上。
1、白细胞计数
正常或轻度增高,血沉增快。
2、痰结核菌
采用涂片、集菌方法,抗酸染色检出阳性有诊断意义。也可行结核菌培养、动物接种,但时间长。结核菌聚合酶联反应(PCR)阳性有辅助诊断价值。
3、结核菌素试验
旧结核菌素(OT)或纯化蛋白衍生物(PPD)皮试,强阳性者有助诊断。
4、特异性抗体测定
酶联吸附试验,血中抗PPD-IgG阳性对诊断有参考价值。
5、胸腔积液检查
腺苷脱氨酶(ADA)含量增高有助于诊断,与癌性胸腔积液鉴别时有意义。
6、影像学检查
胸部X线检查为诊断肺结核的必备手段,可判断肺结核的部位、范围、病变性质、病变进展、治疗反应、判定疗效的重要方法。
 豫公网安备 41110202000246号互联网药品信息服务资格证书:(豫)-经营性-2022-0039增值电信业务经营许可证:豫B2-20221313医疗器械经营备案编号:豫郑食药监械经营备20212188号
豫公网安备 41110202000246号互联网药品信息服务资格证书:(豫)-经营性-2022-0039增值电信业务经营许可证:豫B2-20221313医疗器械经营备案编号:豫郑食药监械经营备20212188号




